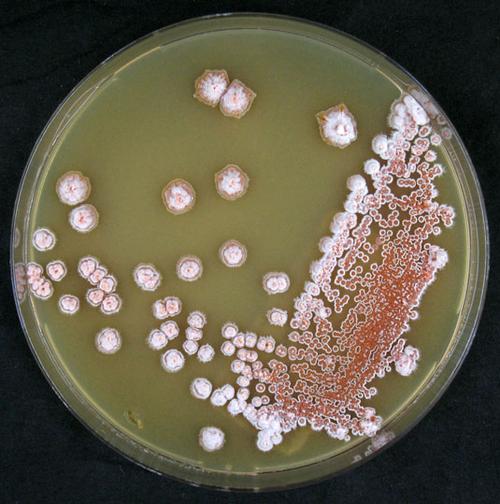
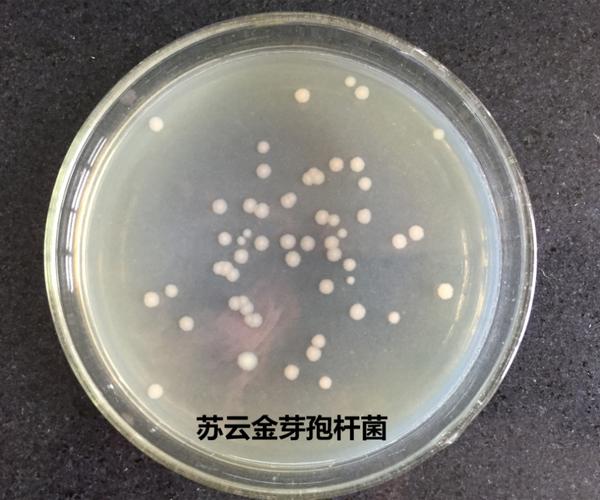

报志愿是一项选择,也是一种赌博。如果选择了一个自己喜欢的专业,那么未来的四年将会充满欢喜;如果选择了一个不喜欢的专业,那么未来的四年可能会充满郁郁不得志的情绪。
如果您想要承担道义,那么您可以学习新闻专业;如果您想要翻译世界,那么您可以选择学习外语;如果您想要勘探山岳江河,那么您可以进入地理学院;如果您认为“功名万里外,心事一杯中”,那么您也可以选择酿酒专业。
如今,各省的高考分数已经陆续公布,这也意味着我们即将迎来填报志愿的时刻。在此,国酒菌诚邀来自天南地北的不同高校的酿酒相关专业的同学与我们一起探讨大学学习酿酒的体验。
对酿酒专业感兴趣的朋友们不妨了解一下,说不定他们就是你或你孩子的学长学姐呢~
一瓶优质葡萄酒的诞生与传承,
从葡萄苗的种植到葡萄酒的酿造,一切尽在掌握。
#刘俊妤#
宁夏大学葡萄酒与园艺学院的葡萄与葡萄酒工程专业,培养了本科生。
01课堂上品酒不再是梦想!

葡萄酒品鉴课。
我们专业开设了一门名为“葡萄酒品尝学”的课程。在课程中,学生们学习如何对葡萄酒进行感官评价,并初步了解世界主要葡萄酒产区和葡萄品种的葡萄酒感官特征。在实操课上,一杯葡萄酒就能带领我们踏遍世界各地的葡萄酒产区。例如,在品鉴室里,每个人都有几个葡萄酒杯,他们从视觉、嗅觉和味觉三个角度依次描述每款葡萄酒。这并不拘泥于理论,而是畅所欲言,有时甚至会用“小时候吃过的某款糖果”或“某款墨汁”来形容葡萄酒。
02探究葡萄酒中的微生物世界!
酵母菌的菌落形态。
在葡萄酒微生物学课程中,学生们将学习原核和真核微生物的形态和生理功能。重点在于微生物在葡萄酒生产中的应用和控制。课程主要分为两部分:酒精发酵中的酵母菌和苹果酸乳酸发酵中的乳酸菌。其中,最令人印象深刻的是酒精发酵中的嗜杀酵母,它能够杀死同种或近缘种的其他酵母(敏感酵母),并可用于保障纯种定向发酵。
03秋分酿酒,做自己的酿酒师!
用手压葡萄。
葡萄酒工艺学的实践内容是“沉浸式”体验如何酿造出一款葡萄酒。每两人一组,分到一个25升的小发酵罐,红色葡萄品种经过机械除梗后放入其中,用手压碎葡萄,加入商业酵母、果胶酶等。冷浸渍4小时后,带皮发酵。几天后,轮流“组队”去发酵车间压帽、测比重,监测发酵情况。当比重降到0.993时,加入偏重亚硫酸钾中止发酵。这样,一款出自自己之手的简单易饮风格的葡萄酒就诞生了!
04走进葡萄园,成为一名高素质的农民!

葡萄藤被绑缚。
葡萄栽培学最有趣的一点是,它能够让我们在葡萄生长季节下到田间实践。每年五六月份,走进葡萄园就像是每个葡萄酒人与葡萄园之间的约定。作为该专业的学生,只有亲身实践才能更真切地理解教材上的理论知识。在绑缚时,我们轻轻地采摘葡萄藤,用绳子均匀地绑在铁丝上,享受阳光。或者,我们剪去新苗的副梢,并寄予主藤“茁壮生长”的期望。这不仅短暂地逃离了城市,还十分治愈。
这些每天都在接触的东西,原来如此丰富多彩。
「原来如此丰富多彩。」
#徐海粟#。
贵州大学酿酒与食品工程学院的食品科学与工程专业,拥有本科生。
01令人惊讶的是,食品专业也要学习酿酒!

到啤酒厂参观。
贵州大学酿酒与食品工程学院拥有食品科学与工程、食品质量与安全和酿酒工程三个专业。这些专业属于工科类,因此学生们需要学习数学、物理、化学和基本实验课程。此外,专业必修课程包括生物化学、物理化学、食品微生物学、食品营养学和食品分析等。此外,还有许多有趣的选修课程,如白酒品评、食品感官评定、果蔬贮藏运销学和焙烤食品工艺学。虽然三个专业的课程有所不同,但都能让学生深入了解每天接触到的几乎所有事物,这种感觉非常奇妙,也能不断刷新学生的认知。
02学习有趣的专业,乐在其中!

「显微镜下的酵母菌。」
作为一个理科女生,我坚信这个专业一定充满乐趣。因此,我毫不犹豫地将其作为我的第一志愿。事实证明,我的选择是正确的!在酿院的课堂上,我们不仅能够学习到美食制作、酒类酿造等知识,还能近距离观察各种形态各异的微生物。此外,学校还为我们提供了丰富的课外活动,如水果拼盘活动和食品创新创意大赛。这些活动让我越来越喜欢和享受这个专业。
03先别喝!这桶酒可是我的毕业论文!

果茶的指标检测。
与其他专业的毕业论文不同,我们专业的同学需要选择食品或酒类相关的课题进行研究。例如,刺梨果酒、酸奶白兰地等,都需要自己酿酒,检测指标,进行感官评定等来获取数据。而对于做毕业设计的同学来说,他们需要设计酿酒行业相关的工厂。这既具有挑战性,又令人感到成就感。
“我对微生物世界着迷,因此...
终于如愿以偿,成为了一名酵母猎人。
#胡双#
中国科学院微生物研究所的微生物学专业,拥有博士学位。
01美酒背后的“酿酒匠”,正是我们的研究对象!
挑选单菌落。
课题组主要从事酵母菌资源、系统进化及酿造微生物组的研究,涉及酿酒酵母遗传多样性、酵母菌分类鉴定与系统发育、白酒酿造过程中微生物组成和功能、大曲真菌生物多样性等研究方向。
酵母菌是一种主要以单细胞形式存在的真菌。人类已经利用酵母菌进行食品发酵近万年,其中最著名的当属酿酒酵母(Saccharomycescerevisiae)。这种真菌分布广泛,在全世界都有发现。它之所以被称为“第一种家养微生物”,是因为它的驯养历史悠久。由于它能够快速降解糖类物质并产生二氧化碳和乙醇,因此被用于生产各种发酵食品,对人类文明发展产生了深远的影响。
02“派大星,我们去采集酵母菌吧!

”老师前往野外进行采样。
在科研过程中,我们经常需要前往全国各地,采集野生环境样品,如树皮、腐木、土壤和果实等。此外,我们还会搜集各具特色的传统发酵食品,如酒曲、面引子、酸奶和豆豉等。通过对酵母菌的分类鉴定,我们可以了解我国酵母菌的多样性,并为酵母菌的开发、利用、保护和研究打下基础。
03真是太棒了,我们成功捕捉到了超级美味的酵母!

富集样品
在分菌过程中,我们就像打开盲盒一样,不知道每一份样品中都有什么酵母。这正是科研探索的魅力所在,当我们发现新种酵母时,都会感到惊喜和着迷。令我印象深刻的是,我们经常能够分离出产香酵母,如酒香、果香和花香等。我们正在研究这些酵母的香气成分和产香机制。此外,酵母菌的外观色彩丰富,形态多样。
自然界中仍有许多酵母等待着我们去发现。这个过程就像是一场持续的狩猎,因此我们自称为“酵母猎人”,希望能捕捉到越来越多的“优秀猎物”!
对于上面几位同学分享的酿酒相关专业的精彩体验,你是否心动了呢?
国酒菌在此提醒各位考生,在填报志愿时,务必仔细评估自己的兴趣爱好,并深入了解各专业的具体情况,以免误解。
最后,祝愿每一位考生都能被心仪的学校和专业录取,在自己感兴趣的领域深入学习,实现对未来的憧憬,收获四年的精彩与激昂!